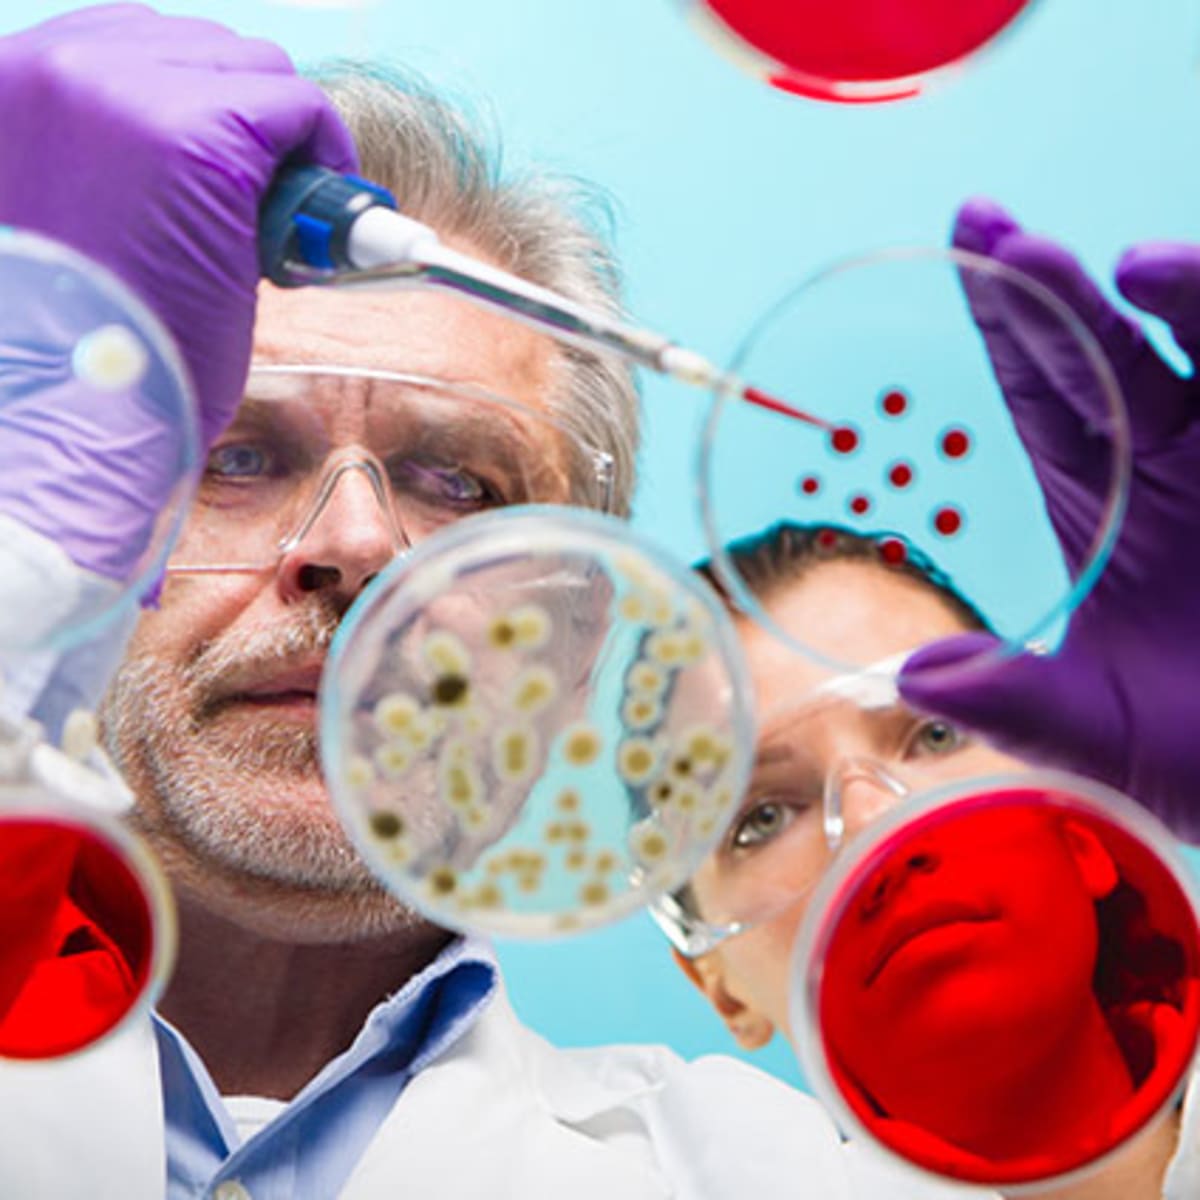

رغم كل سلبياتها كان لجائحة كورونا جانبا إيجابيا غير متوقع، حيث أدى الكفاح ضد الفيروس التاجي لزيادة اهتمام العالم بالعلم في عام 2020 من أي عام سابق، حيث لا يقارن الاهتمام بالعلم هذا العام سوى بعام 1969 عندما هبط الإنسان لأول مرة على سطح القمر.
فعلى الرغم من اختلاف الظروف، يأمل العلماء أن يعزز دورهم في المعركة ضد "كوفيد-19" صورتهم، ويزيد من تمويل الأبحاث ويجذب المزيد من الشباب إلى المهن العلمية، كما فعل برنامج أبولو التابع لوكالة ناسا قبل نصف قرن.
ووفقا لصحيفة "فايننشال تايمز" البريطانية، وقال السير "فينكى راماكريشنان" عالم الاحياء الجزيئي والحائز على جائزة نوبل الذي أنهى لتوه فترة 5 سنوات كرئيس للهيئة العلمية العليا في المملكة المتحدة: "لا شك في أن الاستجابة لكوفيد-19 عزز الاهتمام في العلوم، فإذا كنت شاباً أنظر إلى الطريقة التي توحدت بها العديد من المجالات العلمية المختلفة للعلم بهذه الطريقة التعاونية، لانبهرت بهذا الامر الرائع".
وقالت راشيل يونغمان، نائبة الرئيس التنفيذي لمعهد الفيزياء في المملكة المتحدة، إنه بنفس الطريقة التي عزز بها سباق الفضاء في الستينيات شتى مجالات العلم، مثل الفيزياء والهندسة، من المتوقع أن تؤدي الاستجابة للجائحة إلى تعزيز الاهتمام بنفس القدر.
وأضافت: "أثر كوفيد-19 الاهتمام بفكرة اتباع العلم وعزز صورة العلم عموما، وهناك تركيز مفهوم على علوم الحياة أثناء الجائحة، كما هناك حاجة إلى تعزيز فهمنا بالفيزياء بسبب الدور الذي تلعبه في الرعاية الصحية، مثل تطوير تكنولوجيا الطب الحيوي والتصوير بالأشعة، مما يتيح تحقيق اختراقات في التشخيص والعلاج".
سلطت الجائحة الضوء مباشرة على الإحصاءات والنمذجة الرياضية، وكما قال لاعب كرة القدم الإنجليزي السابق الذي تحول إلى مقدم البرامج الرياضية "غاري لينيكر" على تويتر: "النقطة الإيجابية الوحيدة التي يمكنني التفكير فيها خلال كابوس الوباء بأكمله هو أن بعض الناس تعلمت قراءة رسم بياني".
وقالت تريسي براون، مديرة مؤسسة "سنس ابوت ساينس"، وهي مؤسسة خيرية تناضل من أجل التفكير العلمي السليم: "كان التركيز الإعلامي على العلماء للتحدث عن كوفيد كبيراً، وكان هذا ملحوظا بشكل خاص في الإحصاءات، وفجأة وجد الإحصائيون الكثير من المتابعين على مواقع التواصل الاجتماعي".
وفي عام 2019 أطلقت المؤسسة حملة حول علم البيانات والخوارزميات، وقالت تريسي براون: "كان من الصعب التحدث إلى الجمهور حول هذا الموضوع، والآن يعرف الناس ما نعنيه عندما نتحدث عن النماذج".
ومدحت فيونا فوكس، الرئيسة التنفيذية لمركز وسائل الاعلام العلمية في لندن، تكريس العلماء للكثير من وقتهم لزيادة الوعي عن كوفيد -19 والتواصل مع العامة.
وقالت: "مستوى العلماء الذين يظهرون في وسائل الاعلام بشكل يومي رائعة، فبعضهم كان أفضل في التواصل بكثير من السياسيين، وهو الامر الذي اثبت حجة كنا نتجادل حولها على مدى العقدين الماضيين، وهي أهمية تواصل العلماء مع وسائل الاعلام والعامة.
وقال السير جون هولمان، أستاذ الكيمياء في جامعة يورك ورئيس جمعية تعليم العلوم، إن المدارس والجامعات يمكن أن تتوقع زيادة اقبال الطلاب على دراسة المواد العلمية نتيجة لكل الاهتمام الذي يتلقونه خلال الوباء.
إلا أنه جون يحذر من أخذ معلمو العلوم زيادة الاهتمام كأمر مسلما به، وقال: "قد يكون هناك المزيد من الاهتمام حول العلم الآن، ولكن هناك العديد من العوامل التي قد تؤثر على قرار الشباب حول ما يودون دراسته، حيث يعتبر العامل الأهم هو المعلم ثم آفاق العمل في تلك المهنة".
وقال السير جون إن العامل الحاسم الأخر هو إمكانية الحصول على عمل في مختبرات المدارس والجامعات، والتي توقفت إلى حد كبير نتيجة لتدابير التباعد الاجتماعي أثناء الوباء، والتي يجب استئنافها بأسرع ما يمكن على نطاق واسع.
وأضاف: "يعتبر العمل في مجال العلوم أحد أكبر الدوافع للتخصص في هذا المجال"، مشيرا إلى أن حالة تعليم العلوم يمكن أن تتغير بحسب نتيجة هذا الوباء.
وعلى الرغم من أنه من السابق لأوانه بالنسبة لمعظم النظم الجامعية الإبلاغ عن بيانات موثوقة عن تقدم الطلاب إلى البرامج العلمية في العام الدراسي المقبل، إلا أن احصائيات المدارس الطبية تظهر زيادات كبيرة.
وذكرت دائرة القبول في الجامعات والكليات في المملكة المتحدة أن طلبات الالتحاق بكلية الطب ارتفعت بنسبة 21 % إلى 28690 طلبا.
وقالت الجمعية الأمريكية للكليات الطبية: "إن المتقدمين لدفعة 2021 في ارتفاع كبير، حيث ارتفع العدد بالفعل بنسبة 18 % مقارنة بالعام الماضي".
وشرح ديفيد سكورتون، رئيس المجلس الأمريكي للوباء: "سلط الوباء الضوء على الخدمات الاستثنائية التي يقدمها الأطباء على الخطوط الأمامية".
ابانوب سامي